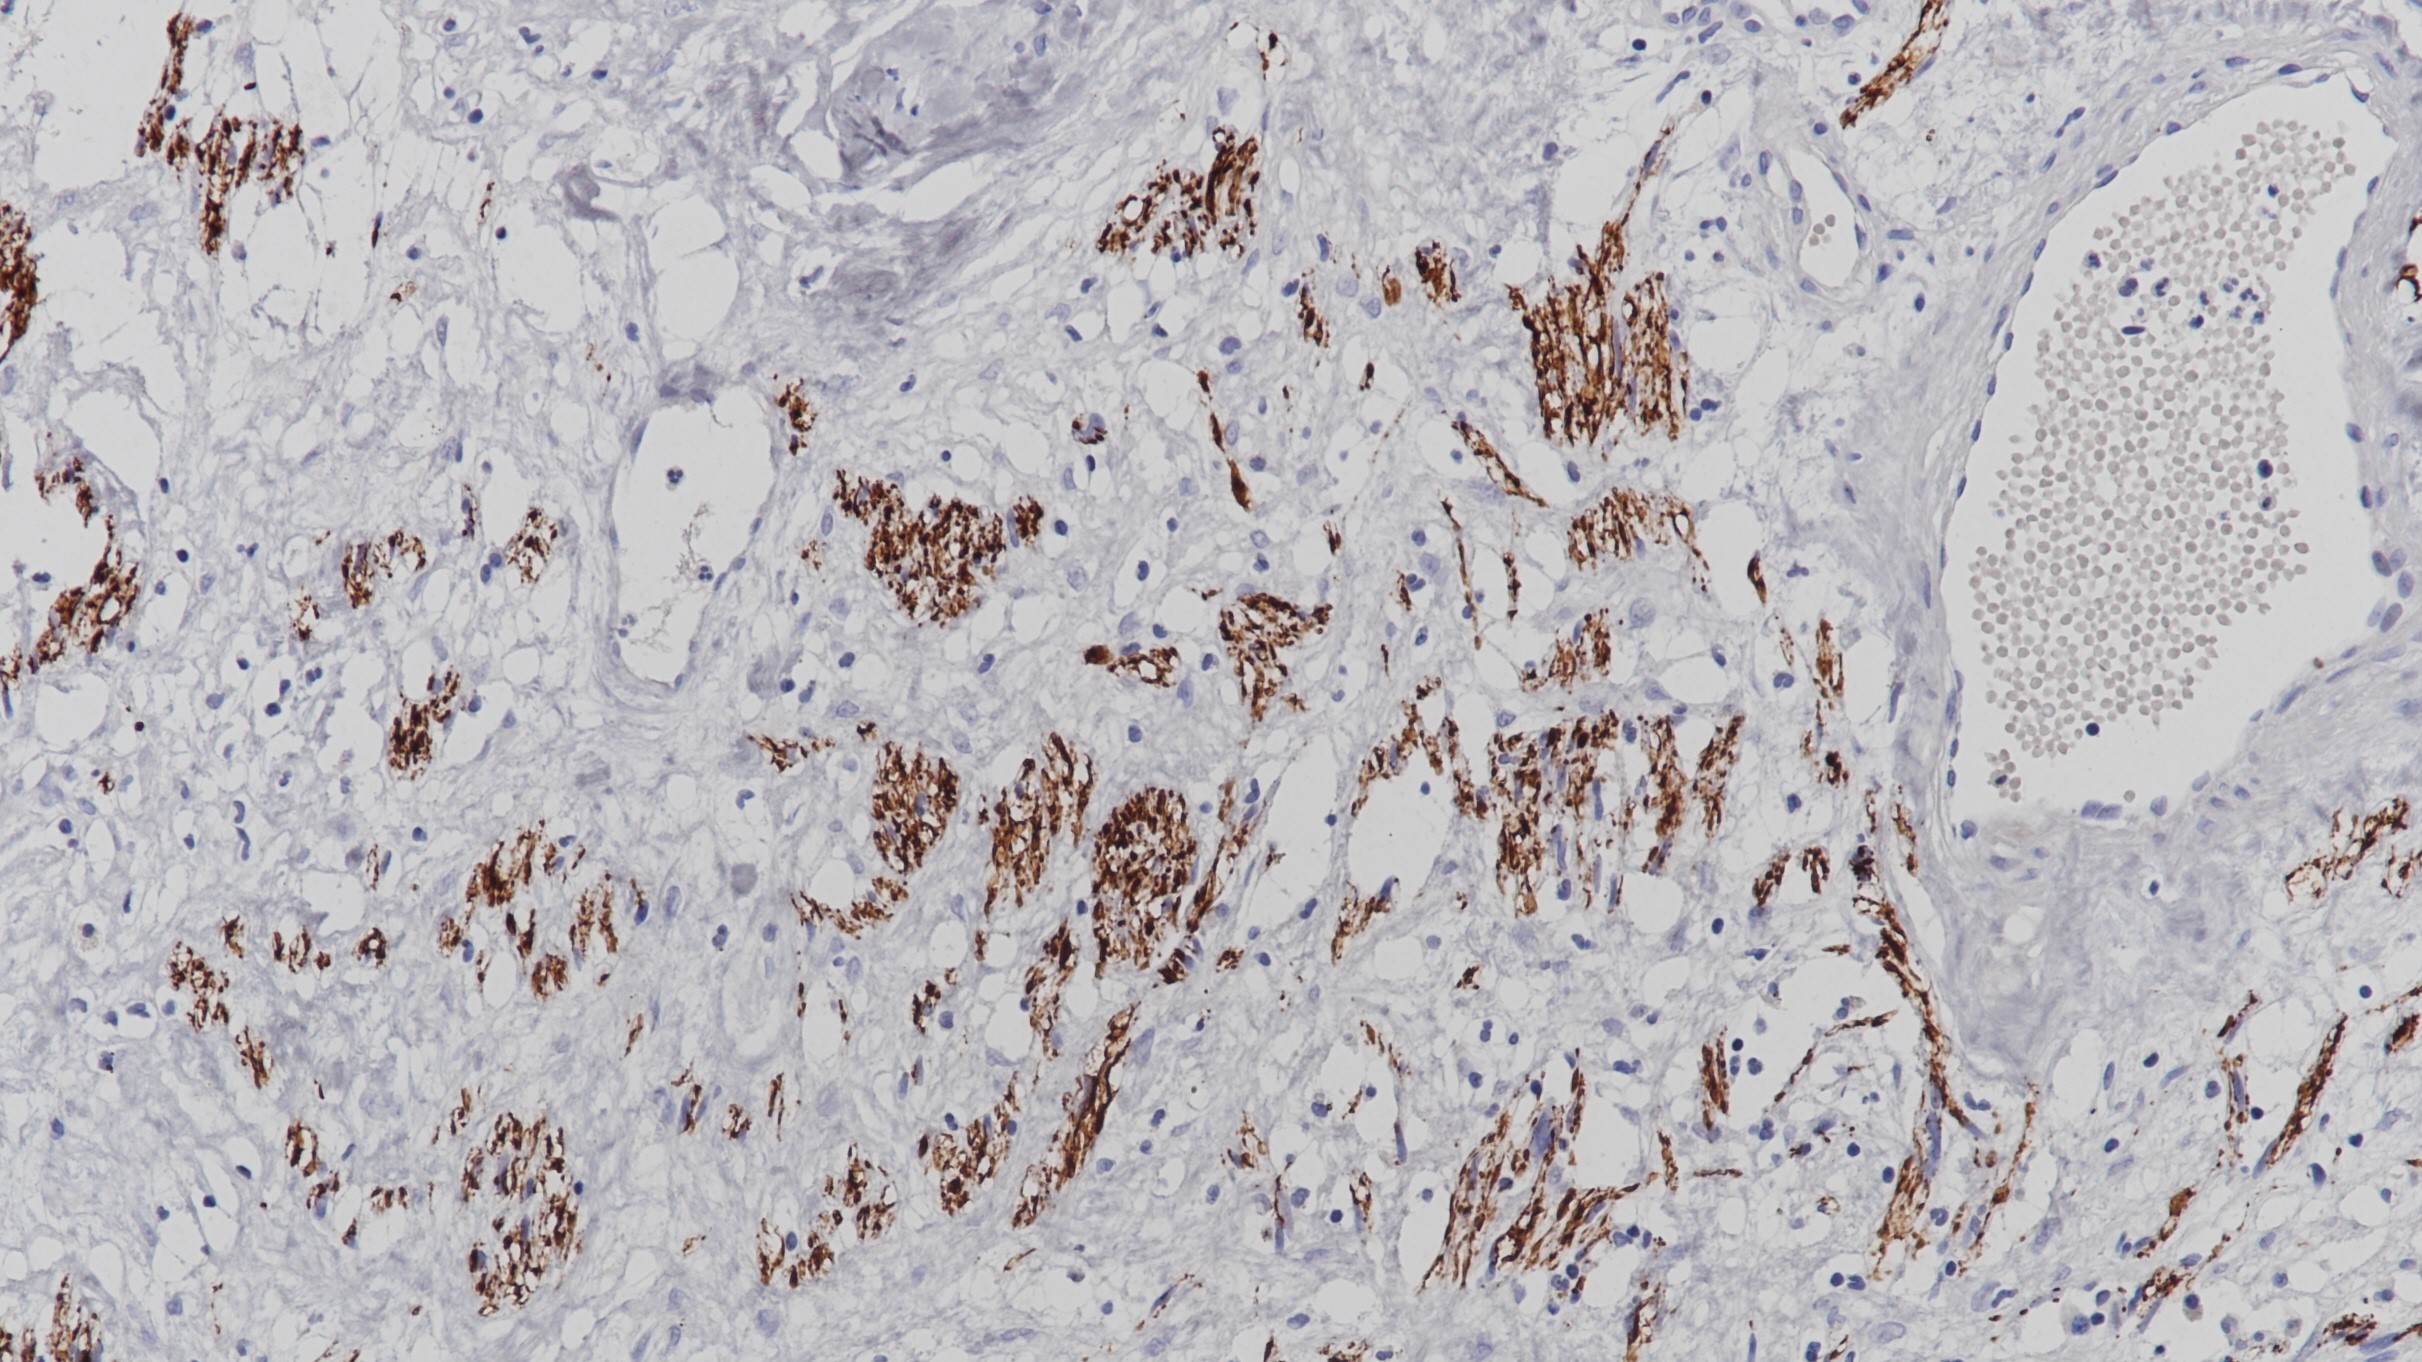
恶性外周神经鞘瘤Neurofilament(2F11)染色

1.Diepholder HM, Schwechheimer K, Mohadjer M, Knoth R, Volk B. A clinicopathologic and immunomorphologic study of 13 cases of ganglioglioma. Cancer 1991 Nov 15;68(10):2192-201.
2.Franquemont DW, Mills SE, Lack EE. Immunohistochemical detection of neuroblastomatous foci in composite adrenal pheochromocytoma-neuroblastoma. Am J Clin Pathol 1994 Aug;102(2):163-70.
3.中华医学会.《临床技术操作规范·病理学分册》.人民军医出版社,2004.